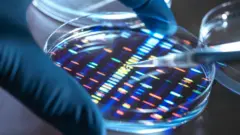
O DNA pode armazenar enorme quantidade de dados e suas necessidades de conservação não consomem muita energia. Por isso, ele pode vir a ser o meio perfeito de armazenamento de dados.

Crédito, SPhotonix
- Author, Laurie Clarke
- Role, BBC Future
Tempo de leitura: 12 min
Durante uma visita ao Japão em 1999, o pesquisador Peter Kazansky encontrou um fenômeno físico misterioso. Agora, ele acredita que esta seja a chave para o futuro do armazenamento de dados.
No laboratório de optoeletrônica da Universidade de Kyoto, os cientistas testavam como escrever em vidro usando lasers ultrarrápidos de femtossegundos. Eles emitem um pulso de luz a cada quadrilionésimo de segundo.
Mas eles observaram algo incomum na forma em que a luz trafegava através do vidro tratado com laser.
A dispersão de Rayleigh é um efeito bem conhecido. Ela descreve como pequenas partículas refletem a luz branca em todas as direções — o que explica, entre outras coisas, por que o céu parece ser azul.
Mas, neste caso, a luz não se refletia conforme o esperado.
“Foi difícil explicar”, afirma Kazansky, professor de optoeletrônica da Universidade de Southampton, no Reino Unido. Ele trabalhava em colaboração com os pesquisadores da Universidade de Kyoto, no Japão.
“Nós observamos a luz se dispersar de uma forma que parecia desafiar as leis da física.”
A desconcertante observação acabou provocando “um autêntico momento Eureka”, segundo Kazansky.
Imagine que você sustente um grosso pedaço de cristal contra a luz e observe como a luz é refletida em muitas direções. Com a técnica do laser, os pesquisadores de Kyoto criaram acidentalmente pequenos orifícios que tinham esta mesma propriedade.
Cerca de mil vezes menores que a espessura de um cabelo humano, esses “redemoinhos” de luz são tão minúsculos que acabam sendo imperceptíveis para o olho humano. Mas logo ficou claro para os cientistas que seu potencial era transformador.
“Esta foi a primeira prova de que podemos usar a luz para imprimir padrões complexos dentro de materiais transparentes, em escala menor que o comprimento de onda da luz”, explica Kazansky.
Agora, 27 anos depois, espera-se que aquela descoberta possa ajudar a resolver um dos problemas mais graves da nossa era da informação: o armazenamento massivo de dados.
Na era da internet, da inteligência artificial, das casas inteligentes e do capitalismo de vigilância, existe algo que simplesmente não paramos de produzir: dados.
A empresa de análises IDC prevê que, até 2028, geraremos coletivamente 394 trilhões de zettabytes de informações todos os anos (um zettabyte equivale a um trilhão de gigabytes).
Toda vez que fazemos qualquer coisa na internet, como assistir a um vídeo no YouTube, enviar um e-mail ou fazer uma pergunta a um chatbot de IA, cadeias de pontos de dados saem em disparada rumo ao ciberespaço.
A ideia de que os dados “pesam pouco” é enganosa.
Nós imaginamos as informações viajando de forma etérea por cabos submarinos ou flutuando suavemente “na nuvem”. Mas, na verdade, elas exigem enormes recursos físicos, cuja demanda está se tornando insaciável.
Os centros de dados consomem quantidades massivas de eletricidade, água e materiais. E seu crescimento exponencial nos obriga a buscar alternativas radicais.
Este dilema vem impulsionando soluções inovadoras. E uma delas é a proposta de Kazansky de gravar dados por meio de lasers.
Outras opções, como a armazenagem de informações em DNA, também estão sendo exploradas por cientistas e empresas como a Microsoft.
Os dados são processados e alojados em centros de dados — estruturas gigantescas, quase alienígenas, repletas de filas de servidores de mais de dois metros de altura, que piscam sem intervalos.
Essas caixas vibrantes de hardware e cabos devoram energia, tanto para alimentar sua capacidade de computação quanto para os enormes sistemas de refrigeração necessários para evitar que elas se incendeiem.
Aliás, um centro de dados não é um lugar agradável para se trabalhar. Quente e ensurdecedor, ele só é adequado para pessoas que conseguem “suportar muitas dores”, segundo uma pesquisa da revista americana The New Yorker em 2025.

Crédito, Getty Images
Em escala global, os centros de dados representam cerca de 1,5% da demanda mundial de eletricidade.
Projeções indicam que seu consumo irá duplicar até 2030, quando também poderão gerar 2,5 bilhões de toneladas de emissões de CO₂. Este número equivale a cerca de 40% de todas as emissões anuais dos Estados Unidos.
A recente expansão da IA generativa agravou a situação. Ela aumentou drasticamente a demanda por sistemas de computação de alto rendimento, que consomem quantidades colossais de energia e emitem nuvens intensas de calor.
A maior parte da energia consumida pelos centros de dados é gasta com “dados quentes”: informações que devem estar disponíveis instantaneamente para acesso rápido e atualizações frequentes. Exemplos são transferências de dinheiro entre contas bancárias e documentos online editados regularmente.
Mas a maioria dos dados do mundo não é deste tipo. Até cerca de 80%, na verdade, são “dados frios”: informações de que ninguém necessita imediatamente e que, quando são necessárias, as pessoas estão dispostas a esperar minutos ou até dias para obtê-las.
Eles incluem dados de conformidade, como registros financeiros ou processos de auditoria, que bancos e outras empresas devem conservar indefinidamente. Também entram nesta categoria as cópias de segurança dos e-mails ou fotos antigas, além de dados de arquivo.
Mas a armazenagem destes dados apresenta problemas.
A maior parte deles é atualmente armazenada em discos rígidos, dentro de centros de dados. Eles devem permanecer ligados para que as informações possam ser recuperadas, o que exige energia e sistemas de refrigeração.
Outra solução cada vez mais popular é a fita magnética. Ela é armazenada nas próprias instalações do centro de dados ou em bibliotecas de fitas especializadas.
As fitas devem ser mantidas sob temperaturas de 16 a 25 °C, o que também implica consumo de energia para manter suas condições ideais.
Além disso, elas precisam ser substituídas a cada 10 a 20 anos devido à sua degradação. Neste momento, a fita antiga é descartada como resíduo.
O enorme aumento da produção de dados impulsionou forte demanda por fitas magnéticas nos últimos anos.
‘Cristais de memória’
Tudo isso faz com que a busca de soluções alternativas seja cada vez mais urgente. E Kazansky está adotando um enfoque inovador sobre este problema.
Nos anos que se seguiram àquela primeira revelação na Universidade de Kyoto, ele descobriu que os redemoinhos com perfurações minúsculas gravadas no vidro podem ser lidos de forma muito similar aos dados transmitidos por fibra óptica.
O professor explica que este método codifica dados em cinco dimensões, empregando a diferença de orientação e a intensidade da luz, combinadas com a localização de diferentes “voxels” (pixels tridimensionais individuais com coordenadas x, y e z).
“Podemos empregar estas propriedades da luz para armazenar dados em cinco dimensões, em vez das três habituais”, explica Kazansky, “o que é fundamental para atingirmos a alta densidade necessária para o armazenamento ‘eterno’.”
As informações são lidas por meio de um microscópio óptico especializado, equipado com uma câmera capaz de detectar a intensidade e a polarização da luz.
“Como as nanoestruturas modificam a forma em que a luz viaja através delas, usamos óptica especial para ‘ver’ essas mudanças de polarização, que são novamente decodificadas em dados digitais”, segundo ele.
Os “cristais de memória” de Kazansky precisam de energia apenas para o processo de escrita dos dados. Mas não é necessário ter energia adicional para sua manutenção e o processo de leitura também não apresenta consumo intensivo.
Eles podem reter uma quantidade vertiginosa de dados em uma área muito pequena. Teoricamente, até 360 terabytes (TB) — equivalentes a 36 mil GB — cabem um disco de vidro de cinco polegadas (12,7 cm).
Kazansky afirma ainda que eles podem durar essencialmente para sempre. Os discos são feitos de vidro de sílica fundida, conhecido pela sua durabilidade e estabilidade térmica.
A única precaução é mantê-los dentro de um recipiente resistente, pois, por serem feitos de vidro, eles continuam sendo susceptíveis às tradicionais quebras.

Crédito, SPhotonix
Em conjunto com seu filho, Kazansky fundou em 2024 uma empresa chamada SPhotonix, para comercializar sua ideia. A companhia completou recentemente uma rodada de financiamento de US$ 4,5 milhões (cerca de R$ 23,2 milhões).
O professor afirma que a SPhotonix já está em contato com empresas de tecnologia para estrear alguns dos seus protótipos em centros de dados durante os próximos dois anos.
Mas, por enquanto, ele destaca que o objetivo continua sendo “aperfeiçoar a tecnologia para garantir que ela seja suficientemente robusta” para estes usos.
Atualmente, a empresa pode atingir velocidade de leitura de cerca de 30 MB por segundo. Mas ela espera aumentar a velocidade de leitura e escrita para 500 MB por segundo nos próximos três a cinco anos, segundo Kazansky.
Em termos de comparação, as soluções mais recentes de armazenamento em fita magnética oferecem até 400 MB por segundo.
“Nossa meta é fazer com que recuperar os dados… seja tão fácil quanto usar um disco rígido moderno”, afirma ele. Mas nem todos acreditam que os cristais de memória representem o futuro imediato do armazenamento de dados.
Para o professor de ciência da computação Srinivasan Keshav, da Universidade de Cambridge, no Reino Unido, um dos problemas é que a tecnologia não é “compatível com a infraestrutura existente”, o que gera “enormes barreiras para sua adoção”.
Kazansky não é o único que estuda como enfrentar o enorme acúmulo de dados do século 21. Ele pode ter encontrado respostas em grãos de areia, mas outros recorreram ao substrato granular de toda a vida orgânica.
Dados em DNA
O físico soviético Mikhail Samoilovich Neiman (1905-1975) foi o primeiro a propor a ideia de usar o DNA como meio de armazenamento, em 1964.
Demonstrações realizadas desde a década de 1980 confirmaram sua viabilidade. Seus defensores afirmam que o DNA oferece uma solução extraordinariamente eficiente e duradoura.
Teoricamente, um único grama de DNA poderia armazenar até 215 petabytes (PB), ou 215 milhões de GB de dados, por milhares de anos. E transformar bytes em bases nitrogenadas é surpreendentemente simples.
“Você pega seus dados digitais e os atribui aos componentes básicos do DNA”, explica o professor de gestão de dados Thomas Heinis, do Imperial College de Londres.
Primeiramente, as quatro letras das bases de DNA (A, T, C e G) são convertidas em 01, 00, 11 e 10.
“Depois, você sintetiza uma molécula (a representação física real desses dados) e a armazena pelo tempo que quiser”, afirma o professor.
A frase favorita entre os pesquisadores do armazenamento de dados em DNA é que “você poderia guardar todos os dados do mundo em uma colherada”, comenta Heinis. Mas ele acrescenta que, na prática, seria muito difícil localizar a informação desejada dentro daquela massa indiferenciada.
O fundamental é que as necessidades de armazenamento não exigem uso intensivo de energia.
Estão começando a surgir startups especializadas em armazenamento em DNA. E, nos últimos anos, houve avanços na redução do custo de “leitura” do DNA, segundo Heinis. Mas o custo total ainda é um obstáculo.
“Continua caro demais”, afirma ele, especialmente em relação à síntese do DNA.
“Na parte da ‘escrita’, ainda não observamos grandes avanços, de forma que isso realmente precisa ocorrer”, segundo Heinis. “Quando for suficientemente barato, tudo o mais irá se encaixar.”
Heinis descreve os cristais de memória de Kazansky como um “concorrente direto do armazenamento em DNA”, mas o DNA poderia ser vantajoso porque “sempre poderemos ler DNA”, devido às suas amplas aplicações médicas.
“Com outras tecnologias, a questão é por quanto tempo existirá o dispositivo de leitura.”
Heinis destaca que, atualmente, é cada vez mais difícil ler meios de gravação como os disquetes, que surgiram nos anos 1970, mas ficaram praticamente obsoletos no início do século 21.
“Existem empresas que oferecem armazenamento de dados por mais de 100 anos. Mas quais delas continuarão existindo daqui a um século?”, questiona ele.
Crédito, Getty Images
Entre as gigantes da tecnologia, a Microsoft é quem demonstrou mais interesse em experimentar novos tipos de armazenamento de dados.
Em 2016, a empresa anunciou ter armazenado 200 MB de dados em DNA, incluindo um banco de sementes do Silo Global de Sementes de Svalbard e a Declaração Universal dos Direitos Humanos em mais de 100 idiomas.
Em 2020, a Microsoft e outras empresas fundaram a Aliança de Armazenamento de Dados em DNA.
“A demanda por armazenamento de dados na nuvem a longo prazo atinge níveis sem precedentes e estamos chegando ao limite do possível com as tecnologias atuais”, declarou à BBC um porta-voz da Microsoft.
A Microsoft também patrocinou o grupo de pesquisa de Kazansky na Universidade de Southampton, como parte do seu Projeto Sílica, entre 2017 e 2019.
“Juntos, demonstramos o princípio fundamental; depois disso, eles continuaram desenvolvendo a tecnologia de forma independente”, segundo Kazansky.

Crédito, Microsoft
Em fevereiro de 2026, a Microsoft publicou um artigo na revista Nature, detalhando um novo avanço neste campo. A empresa conseguiu armazenar dados em vidro de borossilicato, o mesmo utilizado em utensílios de cozinha e portas de fornos, além do vidro padrão de sílica fundida.
O vidro de borossilicato é muito mais barato, o que faz com que a ideia seja economicamente mais viável. E também é muito durável; a empresa afirma que estes dados poderiam ser armazenados por até 10 mil anos.
A Microsoft informou à BBC que, embora seus testes conceituais tenham demonstrado resultados promissores, a empresa ainda não comercializa esta linha de pesquisa.
Repensar a computação
Solucionar o problema do armazenamento de dados a longo prazo é apenas uma parte do desafio representado pelos centros de dados e seu enorme consumo de energia.
A sílica e o DNA são “muito atraentes do ponto de vista da sustentabilidade”, reconhece a professora Tania Malik, da Faculdade de Computação e Cibersegurança da Universidade Tecnológica de Dublin, na Irlanda.
“Mas é pouco provável que estas tecnologias substituam o armazenamento convencional para a informática cotidiana ou as cargas de trabalho de IA em um futuro próximo”, alerta ela.
Malik destaca que existem formas mais práticas de abordar, em curto prazo, o problema do consumo de energia associado aos “dados quentes”.
“Uma questão importante é melhorar a eficiência da infraestrutura, por exemplo, com processadores com uso mais eficiente de energia e técnicas avançadas de refrigeração, como a refrigeração líquida ou por ar externo”, explica ela.
Paralelamente, a professora destaca que existe um “reconhecimento cada vez maior de que a eficiência também deve ser abordada em nível de software e das cargas de trabalho, não apenas em nível de infraestrutura”.
Malik afirma que, “na informática de alto rendimento e na computação em nuvem, o rendimento tem sido tradicionalmente a métrica dominante, mas é preciso considerar a eficiência energética com a mesma importância”.
Para ela, “isso significa projetar algoritmos e aplicativos com consciência do consumo de energia”.
A professora destaca ainda que isso também implica o uso da potência adequada de computação para cada tarefa. Afinal, “nem todas as tarefas necessitam do maior modelo de IA possível, nem do tempo de execução mais rápido”.
Mas, frente ao acúmulo exponencial de dados, é possível que venha a ser necessária uma reorganização mais radical, segundo Malik.
Será que realmente precisamos de todos os dados que produzimos?
Cada vez mais, parte da solução consiste em “termos mais propósito em relação ao que decidimos conservar”, conclui a professora.
Fonte.:BBC NEWS BRASIL


